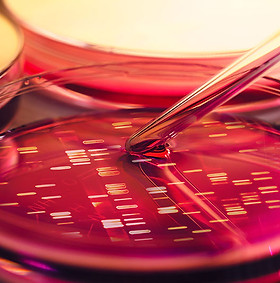
Petri Dish Analysis

Discover

Welcome to ECOSTATys LLC, a premier environmental consulting firm. We provide
knowledge, experience, judgement and perspective for addressing problems in
ecological restoration, population analysis, and endemic species concerns. We collaborate with conservation leaders to enhance our scientific understanding through data analysis and assessment of environmental impact challenges. We offer guidance to resource managers, and create dependable animal population models. Our experience includes terrestrial, aquatic, and estuarine ecosystems.
At ECOSTATys, we have 90+ person-yrs of experience designing, conducting, analyzing and publishing the results of both applied and basic ecological research. Our mission is to work alongside conservation leaders to provide expert guidance, innovative solutions, and reliable population models to ensure a sustainable future for wildlife and ecosystems.

Northern leatherside chub

Stream systems in the Western US are susceptible to periodic droughts the frequency of which is likely to increase due to declining precipitation from climate change. We explored mountain stream system in Southwestern WY with low flows annually and years with dry creek beds. Our aim was to examine the abundance responses of fish in a high elevation stream to the shift from perennial to intermittent flow. The northern leatherside chub (Lepidomeda copei) and four other fish species were studied this system. The northern leatherside chub is considered a species of greatest conservation need in Idaho, Utah, and Wyoming.

Stream

Bacteria are essential to ecosystem function, yet their vast functional and species diversity is often overlooked. Using the information spiraling concept, we developed predictive models of stream bacterial ecology and introduced two terms: colonization distance (D), the furthest downstream point where a new colony can form, and information length (L), the maximum distance over which a gene influences ecosystem processes independently of its host. Our models relate these concepts to average temporal energy load in streams, predicting that energy inputs exceeding biological limits cause downstream energy loss regardless of information length. We further predict shorter information lengths in montane streams than in Coastal Plain streams of the southeastern United States, and that streams with greater energy load variability leak more energy. Overall, temperate streams are expected to use energy less efficiently within a reach than tropical streams.
AB res petri dish

It appears that metal contamination functions as a selective agent for antibiotic resistance genes in environmentally exposed microbes. There are likely several mechanisms that underlie this co-selection process, including co-resistance (different resistance determinants present on the same genetic element) and cross-resistance (the same genetic determinant responsible for resistance to antibiotics and metals). We have explored instances of the acquisition of antibiotic resistance traits among microbes exposed to heavy metals in polluted environments.

UT Lake – June sucker

The June sucker (Chasmistes liorus) is one of 13 species of fish originally endemic to Utah Lake. We have explored via matrix population modeling, likely outcomes of the next 200 years under multiple scenarios of increased climate cycle variation. It is expected that annua precipitation will decline from rising climatic temperatures in the Western US. As a result, Utah lake elevation is likely decline and stream flow variation will increase. The latter can negatively effect recruitment into later life history stages of this fish and the corresponding fluctuations in the annual population size.

Halibut – edible fraction

Pacific halibut (Hippoglossus stenolepis) are a popular sport fish in Alaskan waters. They are also of commercial significance. However, prior research on the expected take home amount (lbs) of each fish caught is sparse. We measured the length and weight of more thab 1,500 of these fish to examine the proportion of the overall weight that was converted to an edible fraction once the fish are cleaned. In addition, we are exploring that application of this concept that to commercial fishing for the species as well.

Sage-grouse

The Greater sage-grouse (Centrocercus urophasianus) has been acknowledged as declining in both its numbers and range in the Western US over the past century. Conservation concern has been expressed regarding the benefit of placing it on the endangered species list. We analyzed a long-term dataset (1948-present) for WY sage-grouse regarding the peak number of males on their leks throughout the state. Our aim was to assess the annual population growth rate, adjusting for the level of year-to-year observation effort, as perhaps a function of cyclic behavior in the Great Basin climate in the inter-mountain west.
Welcome to ECOSTATys – Your Partner in Environmental Research and Statistical Analysis​
​
At ECOSTATys, our team of dedicated scientists and statisticians adopts a customer-oriented approach to provide insights into our environment through quantitative measures.
Dr. Cary Tuckfield, a PhD ecologist with a background in statistics, brings over 35 years of experience in environmental consulting, including two decades at the Savannah River National Laboratory. He has collaborated extensively with Dr. Mark Belk, a BYU biology professor specializing in evolutionary and conservation ecology of native fish, and Dr. J. Vaun McArthur, a retired University of Georgia microbial ecologist known for his work on antibiotic resistance and aquatic ecosystems. Together, they have conducted research on climate impacts, microbial resistance in estuaries, and food safety issues related to E. coli in agriculture. Their combined expertise supports data-driven solutions in ecological research, conservation, and environmental health.
Sponsors







